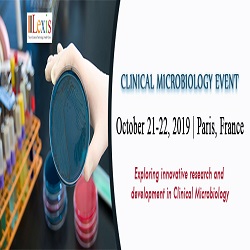
Clinical Microbiology Event

Lexis Conferences feels immense pleasure to organize Clinical Microbiology event with the theme ”Exploring innovative research and development in Clinical Microbiology” which will be held in Paris, France on October 21-22, 2019. Clinical Microbiology Event provides a platform with its well organized scientific program for the audience which includes Keynote session, Panel discussions, Plenary talks, Poster sessions, Workshops, etc. The gathering involves expertise in the field of Microbiology, Epidemiology, Pharmacy, Health-Care and all young researchers and enthusiasts in the related fields. The Clinical Microbiology event includes the latest research and development in the following topics: Clinical Microbiology Pathogenic Microbes Bacterial and Fungal Infection Protozoan and Viral Infection Microbial Genomics Microbial Pathogenesis, Infections Immunity Rare Infectious Disease and treatment Diagnosis and Treatment of Microbial Infections Microbial Immunology Laboratory method in Clinical Microbiology Medical Microbiology Antimicrobial Agents New Microbes and Infections Transmission and Control of Infectious Disease Microbial Biofilms Antimicrobial Resistance Vaccines and Therapeutics Drug discovery Latest Research Techniques in Clinical Microbiology Rapid Next Generation Sequencing of MDR strains For more details about the conference please visit: https://www.lexisconferences.com/clinicalmicrobiology